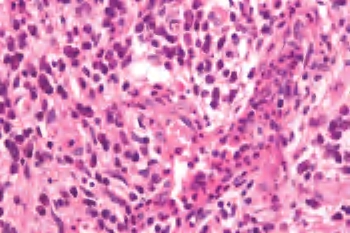

肉芽肿性疾病是一种慢性病,但也有一些发生和发展非常迅速,例如:土伦拉热、耶尔森菌肠系膜淋巴结炎及少见的淋巴结结核。
结核杆菌感染引起的以肉芽肿形成为特点的慢性炎症。可以是全身性结核的一部分,亦可能仅为局限性结核,称为独立性疾病。
临床上患者年龄无特异性,近20年发病率有所增长。全身淋巴结均可受累。
1.肉眼观察 淋巴结直径1~2cm,大者可>10cm。切面灰红色或黄白色,可见干酪样坏死或液化。
2.镜下 典型的肉芽肿中央为干酪样坏死,周边为上皮样细胞、郎罕巨细胞及炎细胞。以免疫反应为主时主要形成肉芽肿,称为增殖性结核;大部分伴有干酪样坏死,称为干酪性结核(图3-13、图3-14)。

图3-13 淋巴结结核,中心大片红染无结构物质为干酪样坏死

图3-14 淋巴结结核,左上方可见一多核巨细胞
3.鉴别诊断
(1)结节病:增殖性结核需与结节病鉴别,后者无干酪样坏死,可见Schaumann小体和星芒小体。
(2)组织细胞性坏死性淋巴结炎:结核早期可与此病混淆,必要时做抗酸染色可有帮助。
(3)霍奇金病:可以伴有非干酪样肉芽肿反应和淋巴结大片坏死,如果忽视R-S细胞和霍奇金病背景,可能误诊。
本病是一种系统性疾病,其病因及其本质至今不明,全身淋巴结均可累及。可能临床毫无症状,或仅有轻度呼吸道症状,其他还可表现为浅淋巴结肿大、全身倦怠及皮肤与眼的病变等。多数患者因胸部X片上出现肺门淋巴结肿大而发现。
1.肉眼观察 淋巴结直径一般<2cm,较硬;切面可散在灰黄色微小斑点,境界较清楚。
2.镜下 密布无干酪样坏死的小肉芽肿,背靠背排列,内含上皮样细胞、多核巨细胞。淋巴结结构部分或全部被破坏,淋巴结纤维化。随着病变发展,即使淋巴结全被肉芽肿取代,其轮廓仍保存而不融合。结节病具有愈合的倾向,肉芽肿可成为玻璃样变的硬化灶。也可见坏死,但只是一小部分的纤维素样坏死而不是干酪样坏死。
Schaumann小体最大径20~50μm,存在于巨细胞内或组织间隙,嗜苏木素着色,组织化学显示其中含铁或钙;星状体大小5~35μm,为蜘蛛状放射形结构,中央为2~4μm的核心,从此核心针状刺向周围放射。此两种小体是非诊断特异性的(图3-15至图3-17)。

图3-15 淋巴结结节病

图3-16 淋巴结结节病

图3-17 结节病中心是Schaumann小体
表现为显著的滤泡增生,伴有广泛大量浆细胞浸润及小灶上皮样组织细胞,包膜及小梁纤维性增厚并伴有淋巴结周围炎,细小动、静脉炎常存在(图3-18、图3-19)。

图3-18 梅毒性淋巴结炎
图3-19 梅毒性淋巴结炎,小血管壁,可见中性粒细胞浸润
形成肉芽肿性淋巴结炎的疾病甚多,包括:非典型分支杆菌淋巴结炎、麻风性淋巴结炎、性病性淋巴肉芽肿、腹股沟淋巴肉芽肿、真菌性淋巴结炎、淋巴结Crohn病、淋巴结Whipple病等。